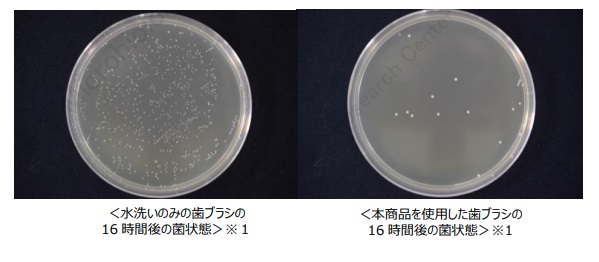

株式会社アイケイ(本社:愛知県名古屋市 代表取締役社長:長野庄吾)は、歯ブラシ専用の除菌
剤『バクテクリン 歯ブラシ専用除菌フォーム』を 2018 年 11 月 5 日(月)に新発売します。
■使用後の歯ブラシが菌の温床に
数百種類の菌がいるとされている、人間の口の中。口内ケアが充分でないと、口内で菌が増殖しすぎてしまい、口臭や口の中の不快感、さらには「歯周病」や「むし歯」、その他の病気などの引き金になることもあると言われています。
歯を磨いた歯ブラシには、口内の菌が付着しますが、そのままにしておくと、「歯石(プラーク)」や「食べかす」を餌にして、歯ブラシの中で菌がどんどん繁殖していきます。
使用した歯ブラシに、なんと 1 億個以上の菌が繁殖していていた人もいます※2。
菌だらけの歯ブラシで歯を磨くことは、毎日口の中に菌を入れていることになり、口内環境の悪循環に陥りかねません。そんな悪循環を断ち切ってくれるのが、『バクテクリン 歯ブラシ専用除菌フォーム』です。
剤『バクテクリン 歯ブラシ専用除菌フォーム』を 2018 年 11 月 5 日(月)に新発売します。
■使用後の歯ブラシが菌の温床に
数百種類の菌がいるとされている、人間の口の中。口内ケアが充分でないと、口内で菌が増殖しすぎてしまい、口臭や口の中の不快感、さらには「歯周病」や「むし歯」、その他の病気などの引き金になることもあると言われています。
歯を磨いた歯ブラシには、口内の菌が付着しますが、そのままにしておくと、「歯石(プラーク)」や「食べかす」を餌にして、歯ブラシの中で菌がどんどん繁殖していきます。
使用した歯ブラシに、なんと 1 億個以上の菌が繁殖していていた人もいます※2。
菌だらけの歯ブラシで歯を磨くことは、毎日口の中に菌を入れていることになり、口内環境の悪循環に陥りかねません。そんな悪循環を断ち切ってくれるのが、『バクテクリン 歯ブラシ専用除菌フォーム』です。

■歯ブラシを軽く水洗いするだけでは菌は落ちない!?
手やお部屋などの除菌ケアに比べると、意外と歯ブラシの菌への意識度は低く、歯を磨いた後は歯ブラシを軽く水洗いで済ませてしまう人もいます。
手やお部屋同様に、歯ブラシも軽く水洗いするだけでは菌は落ちづらいので、しっかりしたお手入れが必要です。
『バクテクリン 歯ブラシ専用除菌フォーム』は、歯ブラシの除菌に特化した除菌フォームです。
水洗いした歯ブラシの水気を切って約 1~2 プッシュし、そのまま 10 分ほど放置。あとはしっかりと洗い流すだけで、歯ブラシについた菌を 99.9%※3 除菌できます。泡タイプなので、しっかり歯ブラシの根元まで届きます。
■歯科医も認める、「歯ブラシケア」の重要性
歯科医や歯科衛生士へのアンケートでも、「歯ブラシは雑菌が繁殖しやすく、歯周病やむし歯菌を広げる原因になることはあると思いますか?」との質問に対し、7 割近くの方が「原因になると思う」と答えています※4。
『バクテクリン 歯ブラシ専用除菌フォーム』は、歯ブラシ除菌がしっかり行えるので、健康管理に役立てていただけます。
手やお部屋などの除菌ケアに比べると、意外と歯ブラシの菌への意識度は低く、歯を磨いた後は歯ブラシを軽く水洗いで済ませてしまう人もいます。
手やお部屋同様に、歯ブラシも軽く水洗いするだけでは菌は落ちづらいので、しっかりしたお手入れが必要です。
『バクテクリン 歯ブラシ専用除菌フォーム』は、歯ブラシの除菌に特化した除菌フォームです。
水洗いした歯ブラシの水気を切って約 1~2 プッシュし、そのまま 10 分ほど放置。あとはしっかりと洗い流すだけで、歯ブラシについた菌を 99.9%※3 除菌できます。泡タイプなので、しっかり歯ブラシの根元まで届きます。
■歯科医も認める、「歯ブラシケア」の重要性
歯科医や歯科衛生士へのアンケートでも、「歯ブラシは雑菌が繁殖しやすく、歯周病やむし歯菌を広げる原因になることはあると思いますか?」との質問に対し、7 割近くの方が「原因になると思う」と答えています※4。
『バクテクリン 歯ブラシ専用除菌フォーム』は、歯ブラシ除菌がしっかり行えるので、健康管理に役立てていただけます。
【商品概要】
商品名:『バクテクリン 歯ブラシ専用除菌フォーム』
容量:30ml
価格:1200 円(税抜)
特長:(1)99.9%除菌※3
(2)プッシュして 10 分置くだけの簡単ケア
(3)ブラシの根本まで届く泡タイプ
(4)マウスピースや入れ歯にも使える
【販売場所】
EC サイト https://item.rakuten.co.jp/deraippai/0915202100/
生協、ドラッグストア、バラエティストア
【商品に関するお問い合わせ】
株式会社アイケイお客様サービスセンター
0120-55-2820
(フリーコール・9:00-17:00 土日祝日除く)
※1 ミュータンス菌を接種した歯ブラシに対する特定の条件下での除菌試験結果(第三者機関調べ)
※2 メーカー調べ
※3 全ての菌を除くわけではありません。
※4 計 16 名にアンケートし 11 名が「原因になると思う」と回答。(メーカー調べ)
商品名:『バクテクリン 歯ブラシ専用除菌フォーム』
容量:30ml
価格:1200 円(税抜)
特長:(1)99.9%除菌※3
(2)プッシュして 10 分置くだけの簡単ケア
(3)ブラシの根本まで届く泡タイプ
(4)マウスピースや入れ歯にも使える
【販売場所】
EC サイト https://item.rakuten.co.jp/deraippai/0915202100/
生協、ドラッグストア、バラエティストア
【商品に関するお問い合わせ】
株式会社アイケイお客様サービスセンター
0120-55-2820
(フリーコール・9:00-17:00 土日祝日除く)
※1 ミュータンス菌を接種した歯ブラシに対する特定の条件下での除菌試験結果(第三者機関調べ)
※2 メーカー調べ
※3 全ての菌を除くわけではありません。
※4 計 16 名にアンケートし 11 名が「原因になると思う」と回答。(メーカー調べ)

【会社概要】
株式会社アイケイは、美しく生きる・健康に生きる・楽しく生きる、の 3 軸をテーマに、長年にわたって
蓄積されたビッグデータから、化粧品・生活雑貨・食品等の商品開発を行い、企画・製造・販売・
物流までを一貫して行う、マーケティングメーカーです。
○社名 株式会社アイケイ
○本社 〒450-0002 愛知県名古屋市中村区名駅 3-26-8
KDX 名古屋駅前ビル5階
○東京支社 〒104-0061 東京都中央区銀座一丁目 7 番 3 号
京橋三菱ビル7階
○代表 代表取締役社長 COO 長野庄吾
○設立 1982 年 5 月 1 日
○資本金 4 億 174 万円
○売上高 183 億 37 百万円(2018 年 5 月期連結)
○従業員 275 名(2018 年 5 月期連結)
○HP http://www.ai-kei.co.jp/
株式会社アイケイは、美しく生きる・健康に生きる・楽しく生きる、の 3 軸をテーマに、長年にわたって
蓄積されたビッグデータから、化粧品・生活雑貨・食品等の商品開発を行い、企画・製造・販売・
物流までを一貫して行う、マーケティングメーカーです。
○社名 株式会社アイケイ
○本社 〒450-0002 愛知県名古屋市中村区名駅 3-26-8
KDX 名古屋駅前ビル5階
○東京支社 〒104-0061 東京都中央区銀座一丁目 7 番 3 号
京橋三菱ビル7階
○代表 代表取締役社長 COO 長野庄吾
○設立 1982 年 5 月 1 日
○資本金 4 億 174 万円
○売上高 183 億 37 百万円(2018 年 5 月期連結)
○従業員 275 名(2018 年 5 月期連結)
○HP http://www.ai-kei.co.jp/




